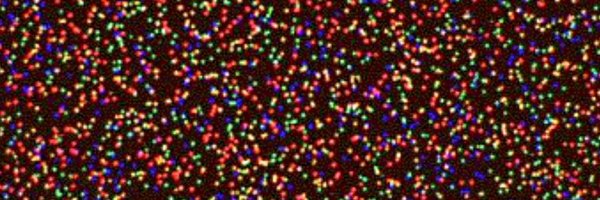
SRsrivatsan Profile Banner

Sanjay Srivatsan
@SRsrivatsan
Followers
2K
Following
12K
Media
76
Statuses
3K
Assistant Professor at @fredhutch. Previously, @UWproteindesign, @uwgenome, and @NIAIDNews. Building sequencing tools to explore biology.
Seattle, WA
Joined December 2013
Today out in @biorxivpreprint we present SCOPE. An optics-free, self-registering array of DNA encoded beads for spatial genomics. This was work led by the intrepid duo of Hanna Liao and Sanjay Kottapalli, with @JShendure's lab.
biorxiv.org
Spatial genomic technologies include imaging- and sequencing-based methods ( [1][1]–[3][2] ). An emerging subcategory of sequencing-based methods relies on a surface coated with coordinate-associated...
7
46
172
We sought to make proteins both potent and FAST. We used #proteindesign to design precise control over protein interaction lifetimes, enabling us to construct rapid-response circuits, biosensors, and switchable cytokines. Now published @Nature! Links to paper and tutorial below.
11
99
459
I’m hiring a PhD student! Come work on #CRISPR + Cancer + T cells 🧬 and help push the boundaries of next-gen immunotherapy. Join us in Copenhagen 🇩🇰 at @DTU_HealthTech !!! Deadline: 30 Sept 2025 https://t.co/XnQ2IuaNPR
efzu.fa.em2.oraclecloud.com
Are you eager to engineer the next generation of cancer therapies using cutting-edge genome-editing in T cells? A fully funded 3-year PhD scholarship is now available at the Department of Health...
2
15
30
Introducing the 1,000 Flower Collection 🧬🌹 I’m creating 1,000 genetically designed flowers each crafted with new colors, patterns, and shapes. Here’s how I’m making it happen… and how you can join me on this journey 🧵(1/7)
14
152
591
A flower designer in the UK ( @NickDesnoyer ) is using breeding, genetic engineering, and even pathogenic infections to create 1,000 original flowers. His name is Nick Desnoyer, and he does this work in his spare time, after his labmates have left for the day. He does not make
14
92
362
Excited to share our work with @julie_trolle and @JefBoeke We developed a 'shotgun' method to screen millions of synthetic metabolic pathways to enable mammalian cells to grow without two essential nutrients for the first time in >500 million years! https://t.co/260aCqjme8
biorxiv.org
Mammalian metabolic engineering is critical to advancing basic biology, bioproduction, and cell therapy. However, as pathway complexity increases, so does the size of both the combinatorial design...
1
7
19
A team of researchers reached into the genome of a seven-month-old baby with a base editing therapy targeted specifically to repair his unique mutation. Now nine months old, baby KJ, as he is known, appears healthy https://t.co/p5rsKuo1qW
https://t.co/OwSYoZT2Si
nature.com
Nature Biotechnology - Despite their astounding success, custom-made base editors and prime editors will need time to broaden their clinical impact.
0
8
32
Please RT🔁 I will be hosting this Synthetic Biology Workshop at @WPI_PRIMe in Osaka on July 15. Great lineup of speakers: @_mattrich, @Lab_Nagai, @CarldeBoerPhD, @nikashakiba, @kenjikamimoto68, @tToshimichiY. The event will be followed by a networking session🥸
1
22
41
Hiring alert! @SRsrivatsan @fredhutch and I @HHMIJanelia are looking for a joint postdoc to combine single-cell omics and ex utero embryogenesis. Please retweet! If you are interested, DM us or send an email to sanjay@fredhutch.org ; alejandroac@janelia.hhmi.org
1
19
37
New preprint! We carried out the largest complementation and inhibition study for diverse homologs in a single protein family (DHFR) to date. Highlights thread follows... 1/n 🧵
Exploring Antibiotic Resistance in Diverse Homologs of the Dihydrofolate Reductase Protein Family through Broad Mutational Scanning https://t.co/LKTdPuMLr2
#biorxiv_synbio
1
13
40
Our annual DSA scientific retreat is just around the corner! We will be celebrating our 2024 DSA winners: @zz_zhaozhang, @WangLabUIUC, @SRsrivatsan, and @crcadwell. If you would like to become a DSA awardee, the application portal is now open! https://t.co/BKNHWu5HvB
1
3
24
Since we announced the FutureHouse AI for Science Fellowship, we've had a bunch more amazing professors sign on as potential co-advisors: Sergey Ovchinnikov (MIT) Ellen Zhong (Princeton University) Patrick Hsu (UC Berkeley/Arc Institute) Pratyush Tiwary (University of Maryland)
4
10
159
We need more programs like this one (@FutureHouseSF) to bring new ideas into the biological sciences. As mentioned in the fellowship link, our lab is excited to co-advise fellows who want to solve the world’s biggest problems with cutting edge tools. DM me if you want to talk
FutureHouse is launching an independent postdoctoral fellowship program for exceptional researchers who want to apply our automated science tools to specific problems in biology and biochemistry, in collaboration with world-leading academic labs. --$125,000 annual stipend.
0
1
14
Grateful for the support of the Sontag Foundation, we’re excited to do this important work!
The Sontag Foundation is proud to announce that Sanjay Srivatsan, Ph.D. from @fredhutch is our second DSA recipient of 2024! His funded project is titled 'Reconstructing Glioblastoma’s Cellular Origins Using Single Cell Genome Sequencing.' #DSA2024 #DSAgrantee @SRsrivatsan
3
1
60
E11 Bio is excited to share a major step towards brain mapping at 100x lower cost, making whole-brain connectomics at human & mouse scale feasible (🧠→🔬→💻). Critical for curing brain disorders, building human-like AI systems, and even simulating human brains. 1/N 🧵
67
415
2K
New work by Mia Yang's lab reports evidence of prevalent aneuploidies in human trophoblast stem cells and suggests that chromosomal instability may be a normal feature of placental development.
1
13
42
I am ***absurdly*** excited to announce the launch of a new funding opportunity through Experiment dot com!!! You have one month to pitch something wonderful in the realm of plant biology/biotech research and education. $10,000 max grant. PLEASE RT!!! 1/3 https://t.co/Jlae6SIQcg
experiment.com
For Science!
5
130
279
Please consider working with us! We have a wonderful growing team and exciting roadmap ahead.
@BrianHie and I also have a joint postdoc position open (for ML and synthetic biology projects), as well as roles in our Technology Centers. Several posted (and unposted jobs!), check out https://t.co/XHugvzdelR to learn more or just contact us anyway
0
6
52
🧵In new work, we report a systematic engineering roadmap to optimize large serine recombinases (LSRs) for direct, site-specific insertion into the human genome 🧬. We achieved over 50% insertion efficiency and 97% genome-wide specificity, a 10X improvement over our previous work
9
82
482
Great faculty position in VIDD @Fredhutch open-strong support from the Bezos family included! Please apply and/or RT!
Join us in accelerating groundbreaking discoveries in #infectiousdiseases and #immunology! Fred Hutch is seeking a scientific leader for the Bezos Family Distinguished Scholar in Viruses and Vaccines faculty position. Learn more and apply: https://t.co/ORIVcuYHkM
0
9
13